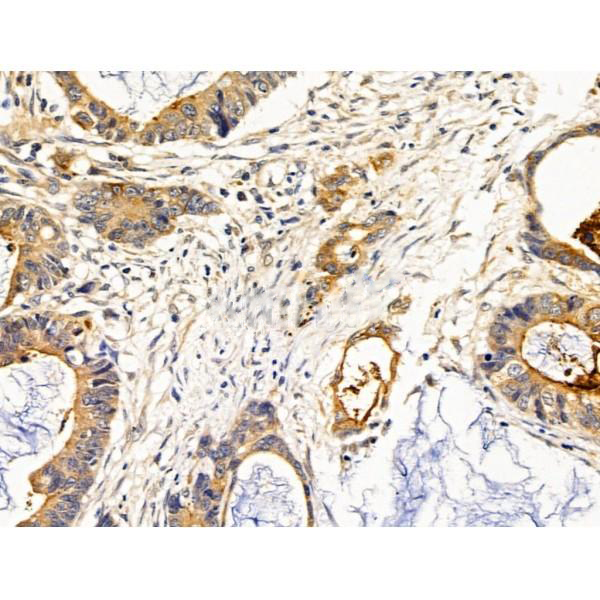

Water channel required to promote glycerol permeability and water transport across cell membranes. Acts as a glycerol transporter in skin and plays an important role in regulating SC (stratum corneum) and epidermal glycerol content. Involved in skin hydration, wound healing, and tumorigenesis. Provides kidney medullary collecting duct with high permeability to water, thereby permitting water to move in the direction of an osmotic gradient. Slightly permeable to urea and may function as a water and urea exit mechanism in antidiuresis in collecting duct cells. It may play an important role in gastrointestinal tract water transport and in glycerol metabolism (By similarity).
Description
Rabbit polyclonal antibody to AQP3
Applications
WB, IHC.
Immunogen
AQP3 Antibody detects endogenous levels of total AQP3.
Reactivity
Human, Mouse, Rat.
可预测:Pig(100%), Bovine(%), Horse(%), Sheep(%), Rabbit(%), Dog(%), Xenopus(%)
Molecular weight
31 kDa(glyco AQP3~ 45kd); 32kD(Calculated).
Host species
Rabbit
Ig class
Immunogen-specific rabbit IgG
Purification
Antigen affinity purification
Full name
AQP3
Synonyms
AQP 3; AQP-3; Aqp3; AQP3_HUMAN; Aquaglyceroporin-3; Aquaporin 3 (GIL blood group); Aquaporin 3 (Gill blood group); Aquaporin-3; Aquaporin3; GIL; Gill blood group;
Storage
Rabbit IgG in phosphate buffered saline , pH 7.4, 150mM NaCl, 0.02% sodium azide and 50% glycerol. Store at -20 °C. Stable for 12 months from date of receipt.
Swissprot
Q92482




 产品订购:
产品订购:
 渠道电话:
渠道电话: